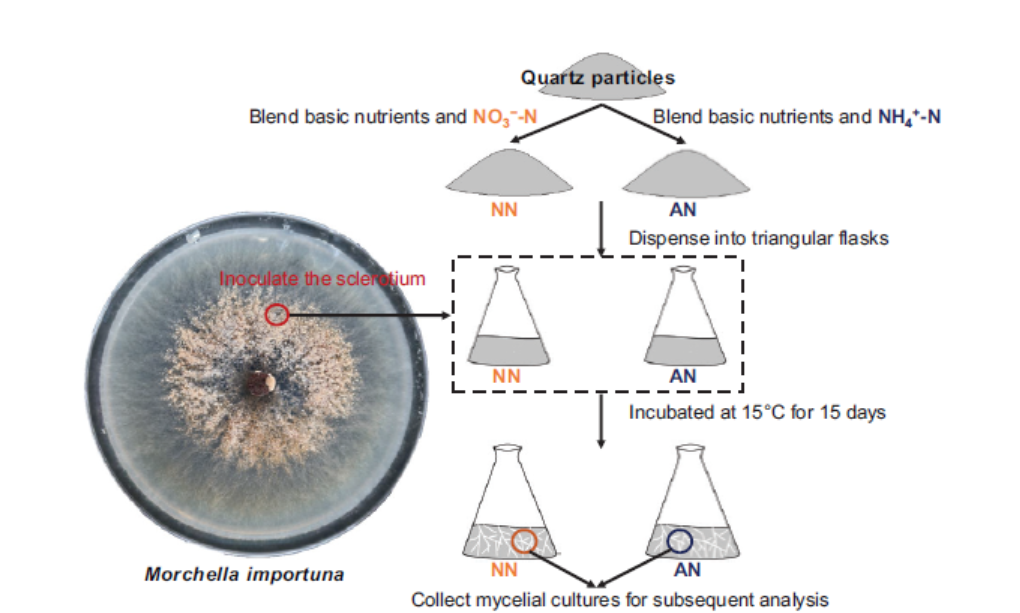

硝酸盐和铵态氮是土壤中两种主要的无机氮形式,大多数大型真菌对特定形式的氮表现出偏好。前期的多项土壤生态研究的结果表明硝态氮比铵态氮更有利于羊肚菌增产,但具体的生理机制尚不清楚。
省食用菌所研究了梯棱羊肚菌吸收同化硝态氮和铵态氮引起的代谢响应差异,运用转录组学、蛋白质组学和代谢组学手段,发现硝态氮抑制羊肚菌菌丝胞内NADP-谷氨酸脱氢酶的基因表达和酶活性,提高了谷氨酸合酶的基因表达和酶活性以及胞内谷氨酸含量水平,揭示了谷氨酸合酶驱动的氮同化途径在硝态氮为主的氮素供应状态下起重要作用。硝态氮导致核糖体生物合成和RNA转运途径相关蛋白表达下调,从而诱导类似于氮饥饿和氧化应激的状态,并进一步引发了与真菌性形态建成相关的代谢改变,例如谷胱甘肽水平升高以对抗氧化应激,酪氨酸酶及其底物表达上调以加速黑色素沉积,以及糖基化增强以促进细胞壁形成等。研究结果有助于羊肚菌学界和产业界进一步深挖氮源差异影响羊肚菌细胞内稳态从而影响营养生长向生殖生长转化的响应机制。
相关研究论文《Multi-omics reveals nitrate-induced oxidative stress and morphogenesis pathways in Morchella importuna》以余洋博士为第一作者、谭昊研究员为通讯作者,发表于真菌领域中科院一区TOP期刊《IMA Fungus》(IF 6.2)。
(省食用菌所 余洋/撰稿 刘颖/校对 林杨/审核)